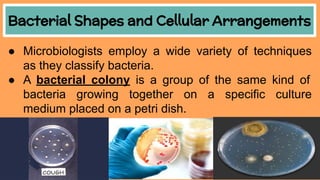
Bacterial Shapes and Cellular Arrangements
● Microbiologists employ a wide variety of techniques
as they classify bacteria.
● A bacterial colony is a group of the same kind of
bacteria growing together on a specific culture
medium placed on a petri dish.

The document provides information about microorganisms. It defines microorganisms as organisms that can be seen through a microscope. It discusses that microorganisms include bacteria, protists, and fungi. It describes some key characteristics of bacteria, including their shapes, structures, reproduction methods, and economic importance. It also explains how some bacteria and protists can cause diseases in humans and other organisms.